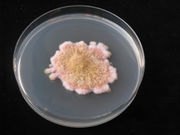

Uploads by Kasa0004
Jump to navigation
Jump to search
This special page shows all uploaded files.
| Date | Name | Thumbnail | Size | Description | Versions |
|---|---|---|---|---|---|
| 11:28, 12 February 2011 | Mould.jpg (file) | |
619 KB | {{Information |Description=mould of some kind |Source=own work |Date=2010 |Author=Kasa0004 |Permission=See below |Other_versions= }} | 1 |
| 11:04, 12 February 2011 | Hund.gif (file) |  |
599 bytes | {{Information |Description= |Source= |Date= |Author= |Permission=See below |Other_versions= }} | 1 |